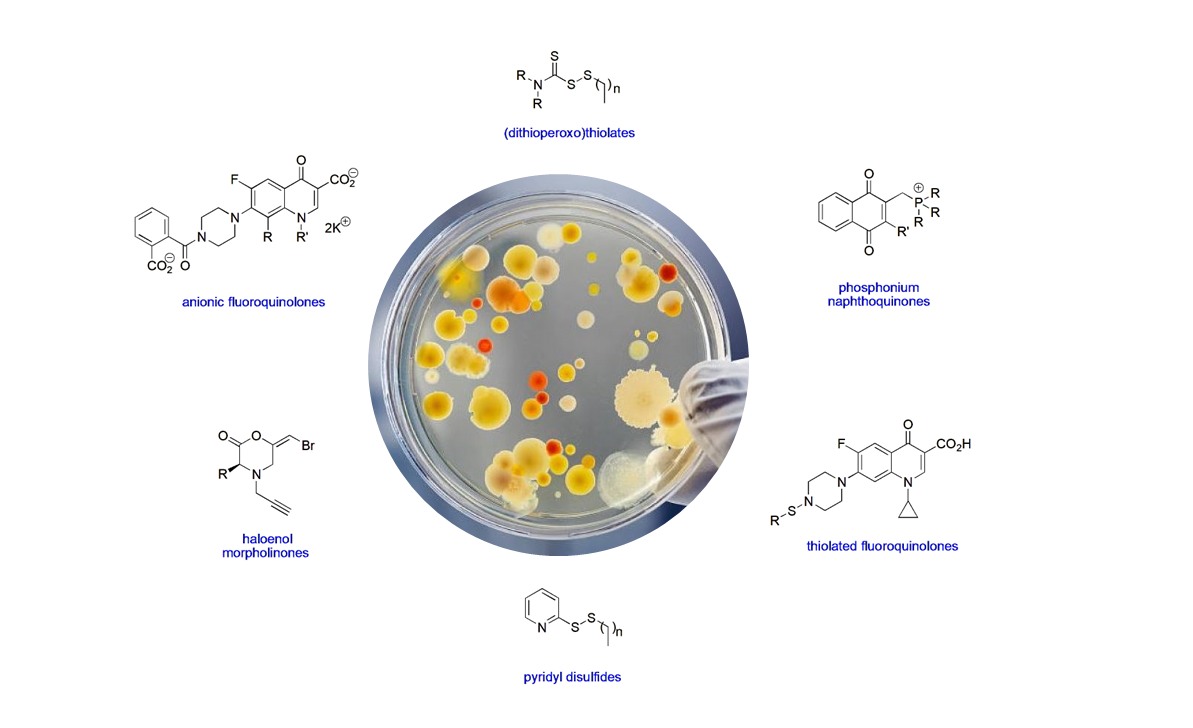

Welcome to the Long Research Laboratory at Marshall University. Our group conducts cross-disciplinary research aimed at discovering and developing new antimicrobials, with a particular focus on vancomycin-resistant bacteria and azole-resistant fungi. Collaborative research efforts involving undergraduate, Pharm.D., M.S., and Ph.D. students has led to original publications on the synthesis and pharmacology of bioactive compounds targeting these clinically significant pathogens.